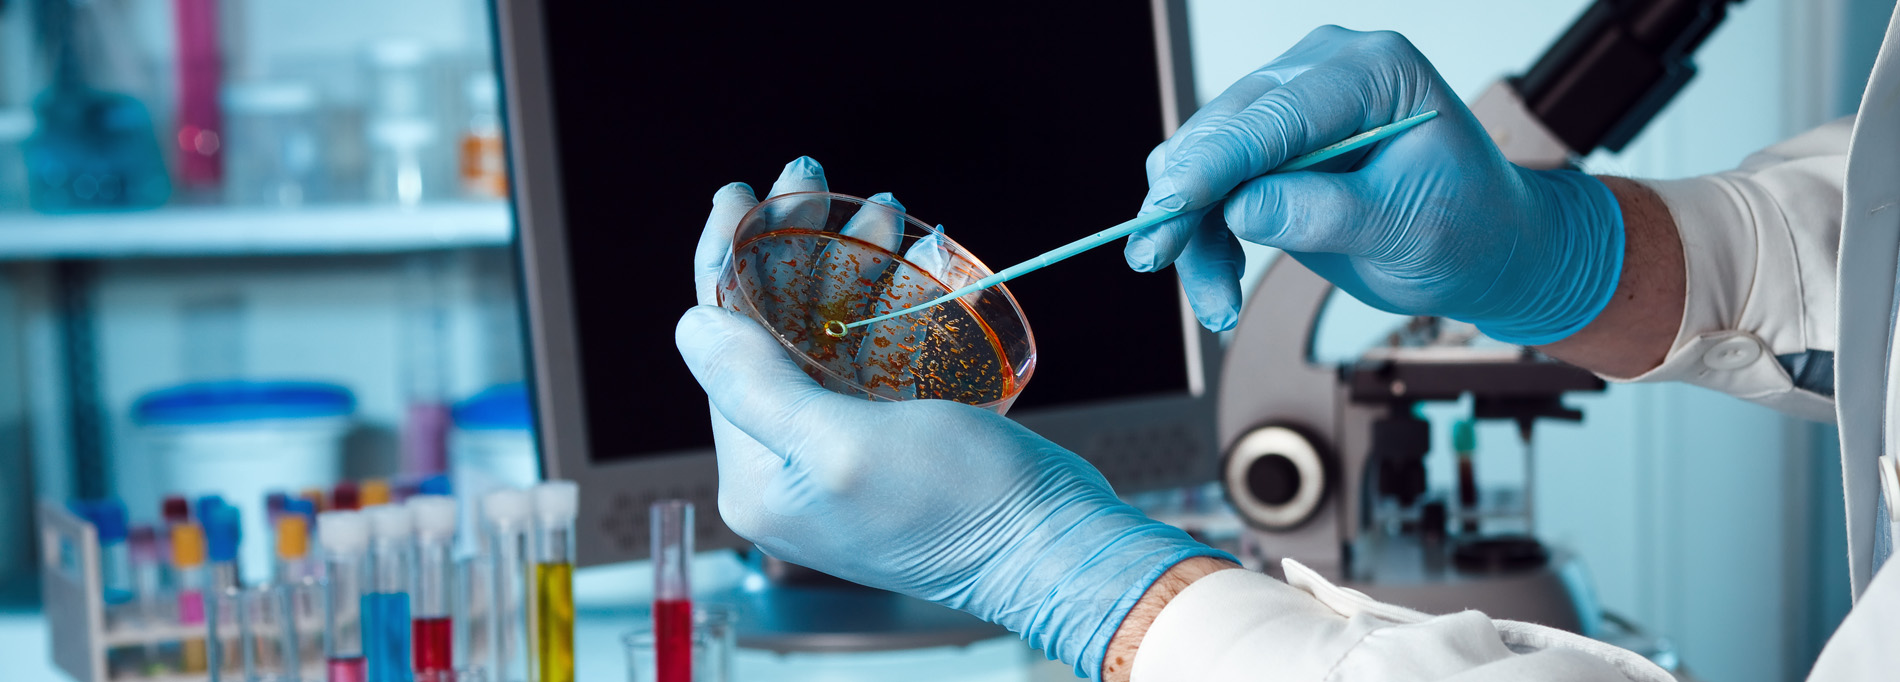
Soigner Medicament

About Soigner
Dedicated to discovery Committed to care
Soigner was established with an intention to take care of humanity by providing world-class medication in reach of everyone. Soigner was established by group of enrich experienced professionals who came together with care and their guiding principles. Our vision is to sky the limit. Today when it comes to quality and affordability of medicine, we have strived to provide world class quality with affordable reach to each individual.
read more



Make an appointment
A better way to practise care, We’d Love to Hear From You, Get In Touch With Us!